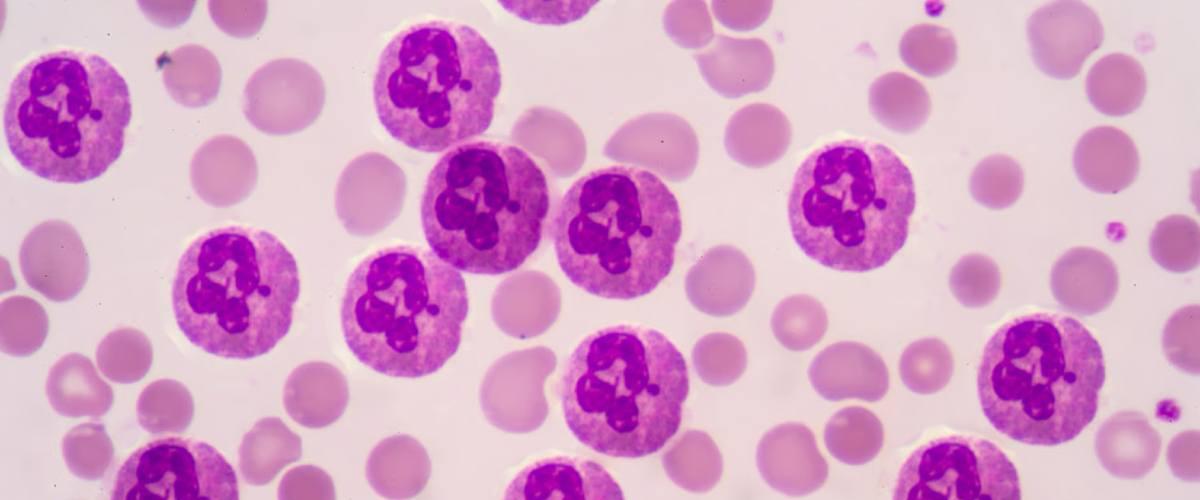
TODO:

В новом исследовании ученые изучили влияние девяти различных молекул ПФАС на врожденную иммунную систему, которые ранее не были хорошо изучены. Команда протестировала вещества на иммунных клетках, называемых нейтрофилами — одними из первых реагирующих на инфекцию организмов. Эти клетки борются с инфекцией, сбрасывая активные формы кислорода на патогены в процессе — это называется респираторный взрыв.
Были протестированы три группы нейтрофилов: одни были культивированы из образцов крови человека, другие получены из эмбрионов рыбок данио, а третьи — из других клеток, которые были химически обработаны, чтобы вести себя как нейтрофилы. Каждая группа подверглась воздействию растворов девяти ПФАС, которые были обнаружены в реке Кейп-Фир в Северной Каролине, а также взяты из крови людей в этом районе.
Один ПФАС оказался особенно проблематичным — GenX. Это более позднее химическое вещество, которым заменили раннее, более токсичное. Было обнаружено, что и оно вызывает проблемы со здоровьем. GenX нарушает процесс респираторного взрыва во всех трех группах, потенциально ослабляя иммунный ответ на патогены. Второй ПФАС, называемый PFHxA, также подавляет этот процесс, но только у рыбок данио и нейтрофилоподобных клеток.
Предыдущие научные работы выявили, что воздействие ПФАС связано с диабетом, низким весом при рождении, проблемами с фертильностью, заболеваниями щитовидной железы и различными видами рака.
Исследование ученых из Северной Каролины раскрывает новые проблемы, связанные с этими и без того проблемными химическими веществами, но необходимо выяснить, как они могут влиять на врожденную иммунную систему на уровнях, которым подвергаются обычные люди. Ученые отмечают, что они анализировали химическое воздействие высокой дозы всего четыре дня, тогда как в реальности такое воздействие длится десятилетиями, но с низкими дозами. Поэтому пока сложно оценить последствия долгосрочного воздействия на иммунную систему.